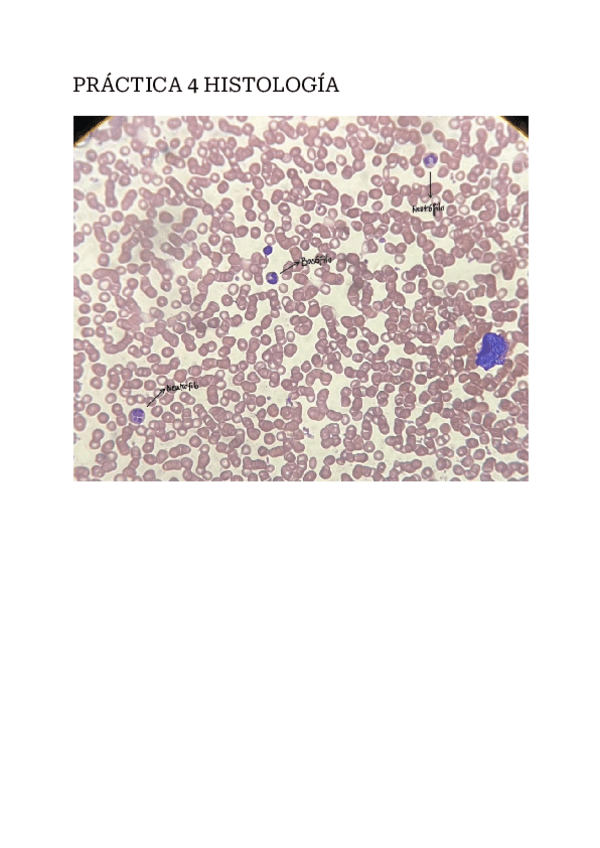

@ilmedus
19 Publicaciones
433 Interacciones
2 Seguidores
3 Siguiendo
Lista de publicaciones de ilmedus
examenes
-
Fisiología Médica I
He publicado nuevos examenes de 2º Fisiología Médica I: Fisiología Médica I
He publicado nuevos apuntes de 1º Histología Humana: Practica-4-Histologia.pdf
He publicado nuevos apuntes de 1º Histología Humana: Tabla-tejido-muscular.pdf
He publicado nuevos apuntes de 1º Histología Humana: Tabla células de la sangre.pdf
He publicado nuevos apuntes de 1º Histología Humana: Seminario-1-Histologia.pdf
He publicado nuevos apuntes de 1º Histología Humana: PRACTICA-2-HISTOLOGIA.pdf
He publicado nuevos apuntes de 1º Histología Humana: Seminario-Histologia-2.pdf
He publicado nuevos apuntes de 1º Histología Humana: Tabla-tejido-cartilaginoso.pdf
He publicado nuevos apuntes de 1º Histología Humana: Tabla-tejido-conjuntivo-no-especializado.pdf
He publicado nuevos apuntes de 1º Anatomía Humana General: Práctica Proyecciones.pdf
He publicado nuevos apuntes de 1º Anatomía Humana General: Práctica Tórax y pelvis.pdf
He publicado nuevos apuntes de 1º Anatomía Humana General: Practica-2-anatomia-general.pdf
He publicado nuevos apuntes de 2º Fisiología Médica I: PREGUNTAS-TIPO-TEST-APARATO-CV.pdf
He publicado nuevos apuntes de 2º Fisiología Médica I: Caso-practico-5-Fisio-I.pdf
He publicado nuevos apuntes de 2º Fisiología Médica I: Caso-practico-1-Bloqueo-AV-ejercicio-practico.pdf
He publicado nuevos apuntes de 2º Fisiología Médica I: Caso-practico-4-Fisio-I.pdf
He publicado nuevos apuntes de 2º Fisiología Médica I: Caso-practico-3-Fisiologia-medica-I.pdf
He publicado nuevos apuntes de 2º Fisiología Médica I: Caso-practico-2-Fisio-I.pdf